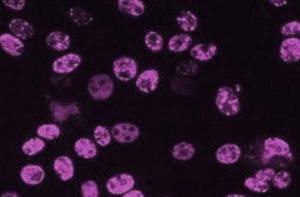

New World Screwworm: Fact Sheet & SHIC Article 6/10/2026 & USDA NWS Website
Pseudorabies Resources: Latest PRV Fact Sheet (Updated June 2024) & Additional PRV Resources/Links & Statement
The Swine Health Information Center, launched in 2015 with Pork Checkoff funding, protects and enhances the health of the US swine herd by minimizing the impact of emerging disease threats through preparedness, coordinated communications, global disease monitoring, analysis of swine health data, and targeted research investments.

Schwartz, Ruen, and Bang elected officers
The Swine Health Information Center welcomed two new board members during their meeting held on July 29-30, 2024. Seth Krantz, DVM, Tosh Farms, and Jay Miller, DVM, The Maschhoffs, began their terms. Founding board member Daryl Olsen, DVM, AMVC, and Russ Nugent, PhD, concluded their service. Nugent joined the SHIC Board of Directors in 2021 and served as president for the year just completed. He was honored for his service with a plaque during SHIC’s June board meeting.
The new SHIC Board of Directors held an election of officers as well. Mark Schwartz, Schwartz Farms, was chosen to lead the SHIC Board as its chair. Paul Ruen, DVM, Fairmont Veterinary Clinic will be the vice chair for the organization and Kent Bang will again serve as secretary/treasurer. Other board members are Joseph Dykhuis, Gene Noem, Jeremy Pittman, DVM, and Pete Thomas, DVM. Megan Niederwerder, DVM, PhD, is SHIC’s executive director and Lisa Becton, DVM, MS, DACVPM, serves as associate director.
New Board Members
Seth Krantz discovered his passion for pigs and the swine industry while in college at the University of Tennessee – Martin. Summer jobs, including at Tosh Farms, and other work experience gave him an appreciation of not only pigs but the people who raise and care for them, leading to veterinary school at the University of Tennessee – Knoxville. After spending two years in practice with Carthage Veterinary Service, Krantz took the opportunity to return home to Tennessee as veterinarian at Tosh Pork. During his career, Krantz has appreciated SHIC’s mission and deliverables to the industry.
“SHIC has been a tremendous resource over the last several years,” he explained. “Certainly, SHIC has been the key resource for veterinarians and producers alike for keeping us abreast of emerging diseases and best practices for emerging diseases.”
Krantz has a lot of appreciation for what the organization does and the service it provides producers. “New and emerging swine diseases are tricky. If we don’t have them in the back of our mind, it could be a problem,” he stated. “SHIC is a key source of resources we will need if we do have to respond to emerging diseases.”
Appointed to the SHIC Board of Directors by the National Pork Board, Krantz was excited to become a part of the organization. “Even in my limited experience so far, I have seen some of the new projects that are being initiated are really fantastic, specifically the work surrounding Japanese encephalitis virus. And really, the quality of the projects and the questions they are answering, and the information delivered out is really exciting, too,” he said.
Serving with industry organizations is important though Krantz says he really likes being a pig farmer more than anything. “I came for the pigs, but I stayed for the people. That’s where I found the most passion for the industry is the people I get to work with and folks raising pigs. It has become the driving force for what I do, the driving force for a robust industry that provides for people and that’s what I’m in it for,” he concluded.
Jay Miller grew up on a central Illinois farm and was very active in 4-H and FFA including a focus on raising and showing cattle. While at vet school at Kansas State University, he discovered an interest in pigs and the swine industry. Miller returned to Illinois where he worked at a traditional mixed animal practice then shifted to become a swine consultant. When it was time to move back closer to home, Miller established his own mixed animal practice which grew to have multiple locations and include five veterinarians.
While serving as a swine consultant, Miller met the team at The Maschhoffs, LLC, which launched a 16-year span of serving them as an advisor before joining them full-time as the director of health. This led to Miller becoming their vice president of health and operations then, in October 2023, president and CEO of the organization.
“While practicing, my passion was really for the success of my clientele,” he remembered. “I felt like I became everything from veterinarian to financial advisor, doing everything to help my clientele be successful.” Miller said he gravitates as much to the business part of an operation as the medicine.
Miller was asked to represent the American Association of Swine Veterinarians on the SHIC Board of Directors. “When Harry Snelson (AASV executive director) asked me to be part of the SHIC Board for AASV, I was absolutely excited to be part of it,” Miller stated. “Paul Sundberg was instrumental along with Daryl Olsen and the original board in establishing SHIC. And SHIC interacted with The Maschhoffs several times as they were working on the issues of biosecurity, emerging disease, and the PED outbreak. We were fortunate to have direct exposure to SHIC in those ways.”
One of SHIC’s strengths, per Miller, is connecting academic research to the producer. “I’m a big believer that you need to make decisions based on accurate information and facts. In this industry, the biological protein industry, it can be difficult to get to the bottom of issues and find the cause of problems. And I see The Maschhoffs as being a science-based biological protein company. SHIC has supported the industry in the same manner, using science to help solve problems and inform decisions for producers while understanding the economic impact of these issues to producers and the industry,” he observed.
Founding Board Member Daryl Olsen
Olsen saw the need and potential for SHIC when established in 2015. A member of its board of directors from day one, Olsen also served as the organization’s president for eight years. “In the very short time we’ve been in existence, we have come to play such a vital role in helping defend the health of our industry. I recommend people evaluate our performance. You’re going to understand that since receiving initial funding from the National Pork Board, we have filled a void and been very successful. We’re committed to protecting the US pig population,” he observed.
During his tenure with SHIC, Olsen credits his fellow board members, working group members, and staff for helping reach the goals set out when it was created. “I have been able to work with great people,” he remarked. “Paul and Megan are outstanding. And the board members I’ve served with have been great.”
While honored to be part of SHIC’s growth and contributions to the swine industry, Olsen believes having new board members adding their perspective and expertise is appropriate. Plus, he says, he will be able to be involved in the industry in new places.
To recognize his service to SHIC and the swine industry, Olsen was honored at the recent SHIC board meeting by current board president Mark Schwartz with a presentation and plaque.

Efforts inform preparedness and response planning for pork producers and veterinarians
A multistate outbreak of HPAI Type A (H5N1) in dairy cows began on March 25, 2024, in Texas. The cross-species outbreak immediately drew the attention of pork industry organizations whose representatives began collaborating for a cohesive, coordinated – not duplicative – effort to be informed, engaged, and responsive on behalf of the pig farmers and practitioners they represent and serve.
“Since H5N1 was identified in dairy cattle, there’s been constant collaboration and communication between partners in the pork industry. The Pork Board has been meeting at least weekly with stakeholders from the Swine Health Information Center, the American Association of Swine Veterinarians, The Meat Institute, the National Pork Producers Council, the USDA, and others to closely monitor H5N1 updates and response within the dairy industry. These meetings give us the opportunity to discuss the potential implications and possible response,” remarked Dr. Marisa Rotolo, veterinary epidemiologist, director of swine health, National Pork Board.
As of July 7, 2024, H5N1 had been confirmed in dairy cattle in 12 states. This includes 28 herds in Idaho, 25 in Michigan, 27 in Colorado, 21 in Texas, 12 in Iowa, eight in New Mexico, seven in Minnesota, five in South Dakota, four in Kansas, and one each in North Carolina, Ohio, and Wyoming, per USDA’s Animal and Plant Health Inspection Service. H5N1 has not been found in pigs.
In an opinion piece by US Secretary of Agriculture Tom Vilsack titled, Good Biosecurity Is the Key to Mitigating the Spread of H5N1, released on June 26, 2024, he wrote, “The more we learn about H5N1, the more we understand that good biosecurity is a critically important path to containing the virus. Containing, and eliminating, the virus in our dairy cattle is essential – to protect the health of our herds and flocks, our farmers, our farmworkers, our families, and the rural economy they make possible.” Pork industry representatives support efforts being made by the dairy and poultry sectors, while looking for lessons in their experience to apply in the event it is needed for pigs.
Collaboration Is Critical
Collaboration is critical for preparedness and response, not only with other pork organizations, but within the barnyard and beyond. “We have those relationships in place and communicate almost daily with our colleagues in other pork organizations, and frequently with those working in animal health, human health, and the regulatory space,” said Abbey Canon, DVM, MPH, DACVPM, director of public health and communications with the American Association of Swine Veterinarians
Part of AASV’s mission is to increase the knowledge of swine veterinarians, protect and promote the health and well-being of pigs, and advocate for science-based approaches to veterinary, industry, and public health issues. Dr. Canon says the organization strives to disseminate the most up-to-date information that swine veterinarians need and can use or distribute to their clients.
Leveraging Lessons Learned
Preparing for and responding to livelihood-damaging endemic and emerging swine disease, including influenza, is nothing new for the pork industry. “The pork industry is not a stranger to managing new and novel influenza strains. We learned a lot from H1N1 in 2009, which resulted in a lot of good planning between industry stakeholders and federal and state government agencies which can serve as the foundation for a measured and appropriate response to the introduction of different strains in the future,” remarked Dr. Patrick Webb, assistant chief veterinarian, National Pork Board.
Existing preparedness programs developed for the swine industry serve multiple purposes. “While the swine industry has had a particular focus on African swine fever and other foreign diseases, much of this work and preparation benefits current conversations about H5N1. Examples include enhanced biosecurity protocols as part of the Secure Pork Supply plan, development of the Certified Swine Sample Collector program to improve our surveillance capacity, and improvements to live swine traceability with the swine traceability standards supported by producers at National Pork Forum. The industry recognizes that there are multiple threats to swine health and in response, has invested time, money and resources into improving our readiness,” explained Anna Forseth, DVM, MS, director of animal health,National Pork Producers Council
“The swine industry has been monitoring the evolving H5N1 situation closely. We know that new or novel strains of a virus can raise questions and activity beyond how it impacts the animals themselves, including regulatory action and impacts to trade. As we watch the dairy industry’s experience, we are engaging in conversations with state and federal regulators, public health officials, diagnostic laboratories, and trading partners to educate decision makers about the swine industry,” Dr. Forseth said.
Informing the Pork Industry’s Preparedness and Response
The Swine Health Information Center was founded in 2015, after the porcine epidemic diarrhea virus outbreak of 2013 when resources and response were determined to be inadequate. Resulting work of the Center has informed the industry’s response, preparation, and preparedness efforts surrounding emerging disease issues, including H5N1.
“The recent detection of HPAI in domestic livestock raised questions regarding the emerging threat and potential risks for swine herds. The Swine Health Information Center, along with the American Association of Swine Veterinarians, hosted a webinar April 19, 2024, on influenza A viruses, with the goal of informing producers about influenza A virus pathogenesis, distribution, surveillance and research including the H5N1 outbreak. The webinar highlighted practical steps producers could take to reduce the risk of avian influenza on their farms, with a focus on biosecurity considerations to decrease wild bird access, and outlined the outbreak investigation tools available through SHIC for use during suspected health challenges,” explained Megan Niederwerder, DVM, PhD, executive director of SHIC.
SHIC provides additional tools for practitioners and producers to employ in preparedness efforts as well. “Swine producers and their veterinarians are very familiar with surveillance and management of influenza A viruses in their herds and the detection of H5N1 in dairy cattle highlights the continued importance for IAV surveillance. The Swine Disease Reporting System, funded by SHIC, provides information and tools that can be applied for use in decision making on farms. Monthly domestic disease monitoring reports detail the detection of influenza A virus across six veterinary diagnostic laboratories and represent >96% of U.S. swine sample submissions, enabling producers to rapidly detect new viruses, track changes over time and by region, and inform decisions for management strategies,” stated Lisa Becton, DVM, MS, DACVPM, associate director of SHIC.
One Health Perspective Incorporated in Collaboration
Influenza has indeed been present in the U.S. swine industry for decades with multiple strains impacting herds. “AASV recommends pork producers, swine veterinarians and diagnostic laboratories actively participate in IAV surveillance programs that provide information regarding influenza A virus evolution and epidemiology. Participation in these surveillance programs can help identify and quickly respond to emerging threats with early detection,” stated Dr. Canon. “Further, AASV supports the recommendation that people working with swine take all available precautions, including vaccination (with their human health professional’s approval), biosecurity, and personal protection measures to work towards prevention of bidirectional influenza transmission. It is important to consider cross-species transmission of influenza viruses as part of a One Health approach.”
Following the discovery of H5N1 in dairy herds, four human cases of the influenza strain have been detected in people, per the U.S. Centers for Disease Control and Prevention “This is a great reminder for the industry of how important our seasonal flu shots are. Since pigs can contract influenza strains from humans, keeping workers healthy also keeps pigs healthy. Everyone who works with pigs should be getting their annual flu shot,” commented Dr. Heather Fowler, public health veterinarian, director of producer and public health, National Pork Board.
Preparing for Outbreak Together
“The current influenza outbreak is a great example of how important a One Health approach is when dealing with illnesses that affect both humans and animals in a shared environment. Since the identification of the H5N1 virus in dairy cattle, the Pork Board has been working collaboratively with partners across the barnyard to help us prepare if we were to have an introduction of H5N1 into the swine herd,” said Dr. Fowler.
“The swine industry already has extensive knowledge and experience when it comes to flu management and monitoring. We have multiple programs that can be quickly deployed should H5N1 be detected in swine,” Dr. Rotolo observed. Existing programs combined with intentional preparedness efforts equip the pork industry to deploy an effective response to H5N1 in the U.S. swine herd if needed.
Porcine circovirus associated disease presents a significant challenge to swine health and pork production globally. Multiple types, including PCV2 and PCV3, have worldwide distribution. Since first being described in 2019, PCV4 has been detected in Asia and Europe but not previously in the US. In a study funded by the Swine Health Information Center, PCV4 was detected for the first time in US clinical samples submitted to the Iowa State University VDL from June to September 2023. Led by Dr. Pablo Pineyro at Iowa State University, this study provides initial insight into the frequency of detection, tissue distribution, and genetic characterization of PCV4 in the US. Further studies to understand PCV4 prevalence as well as its role in coinfection and production losses are warranted to assess its importance and perhaps economic impact in the swine industry. The study has been published by the journal Nature Scientific Reports and is available at nature.com as well as here.
Objectives of this study included (1) characterizing the detection rate of PCV4 across different sample types from clinical submissions, (2) comparing molecular features of US PCV4 ORF2 sequences to reference strains, (3) characterizing the co-detection rates by direct and indirect methods for PCV2, PCV3, and other endemic viral and bacterial pathogens in PCV4 positive samples, and (4) identifying the tissue distribution and immune cell types which facilitate PCV4 replication by direct detection methods. Overall, PCV4 was detected in 8.6% of samples tested with an average PCR Ct value of 33. Lymphoid tissue had the highest detection rate (18.7% positive) and PCV4 was most commonly identified in nursery to finishing aged pigs displaying respiratory and enteric disease. Co-infection with PCV2, PCV3 and other endemic swine pathogens was frequently observed.
To accurately assess PCV4 tissue distribution, the study utilized 512 porcine lung, feces, spleen, serum, lymphoid tissue, and fetal tissue samples submitted for routine diagnostic investigation to the ISU VDL from June through September 2023. Samples were randomly selected to be representative of those used to evaluate different clinical syndromes. PCV4 was detected in 44 of the 512 samples evaluated (8.6%) with positive results in lung (9%), feces (5%), spleen (9%), serum (10%) and lymphoid tissue (17.2%) but was not detected in fetal samples. PCV4 PCR Ct value ranged from 21.3 to 36.2; the average Ct value for different sample types was not significantly different. Direct detection by in situ hybridization confirmed viral replication in lymph nodes and the lamina propria of the small intestine.
Fetal samples tested in the current study were negative for PCV4, including tissues from aborted fetuses, mummies, and stillbirths. However, previous studies from other countries have reported the detection of PCV4 viral DNA in aborted fetuses from sows with reproductive failure. Further studies are needed to investigate and characterize the presence and significance of PCV4 detection in tissue from aborted fetuses and stillbirths to evaluate its potential role in reproductive failure. The researchers noted that PCV4 tissue tropism may differ from PCV2 and PCV3, thereby resulting in potential differences in clinical presentation and lesions associated with infection.
Two complete PCV4 ORF2 sequences were obtained from positive lymphoid tissue samples with a Ct value of 21.3 and 25.6. To understand the potential origin of PCV4, the two complete US ORF2 sequences were compared to 73 reference PCV4 ORF2 sequences obtained from GenBank including those sequences of Spanish, South Korean, Tai, Chinese, and Malaysian origin. One strain had 98.98% nucleotide identity with a 2022 Spanish sequence and the second had 98.69% nucleotide identity with a 2020 South Korean sequence. The phylogenetic analysis revealed relatively high nucleotide identity between US sequences and reference sequences from other countries, suggesting potential global dissemination of PCV4 strains.
Researchers reported PCV4 detection was most commonly observed in nursery to finishing aged pigs displaying respiratory and enteric disease. Frequent co-infection with PCV2, PCV3, and other endemic pathogens was observed, with researchers noting this highlights the complex interplay between different PCVs and their potential roles in disease pathogenesis. All samples were analyzed for the presence of PCV2, PCV3, and PCV4 viral DNA by qPCR. The rates for single detection of PCV4 (3-5%) and co-detection of PCV4/2 (2-4%) were similar for lung, feces, spleen, and serum. Additionally, data showed lymphoid tissue displayed the highest detection rate for PCV4 single detection (10.9%) and PCV4/2 co-detection (4.7%). The PCV4/3 co-detection was relatively infrequent and only confirmed in 1% of lung and serum samples.
For respiratory cases with PCV4 detected, co-infections with PCV2, Streptococcus suis, and PRRSV were most frequently identified. In the instance of PRRSV and PCV4 co-infection, co-detection of the viruses occurred in the lymph node but not in the lung. For enteric cases, Escherichia coli and Salmonella species were most commonly identified with seven and three detections, respectively.
Although the pathogenesis of PCV4 remains poorly understood and its role in clinical disease and production losses is still unknown, findings of the study confirm the presence of PCV4 in the US. Further research is warranted to elucidate the pathogenic mechanisms and clinical implications of PCV4 infection, and the interaction of PCV4 with other pathogens in pigs. This study underscores the importance of ongoing surveillance and research efforts to better understand and mitigate the impact of PCV4 as a potential emerging pathogen to swine health and production.

Although visual inspection is a commonly used tool in the industry to assess farrowing room cleanliness after cleaning and disinfection, visual inspection is often insufficient to confirm the absence of pathogens and reduce disease transmission risk. In a study funded by the Swine Health Information Center and led by Dustin Boler at Carthage Innovative Swine Solutions, adenosine triphosphate (ATP) bioluminescence technology was investigated as an objective diagnostic tool for producers to ensure farrowing room cleanliness. Across five farrowing crate locations and the room entry floor testing, the areas of highest concern were the sow feeder and the entryway floor as detected by both ATP bioluminescence and bacterial coliform plate counts (CPC). Overall, this study confirmed that ATP bioluminescence technology can be used as a monitoring tool for ensuring farrowing room cleanliness and identified the highest risk areas in the farrowing room for contamination. Find the industry summary of the project, SHIC 24-001, here using the search feature.
Pig producers have adopted cleaning procedures and biosecurity practices to ensure farrowing rooms are free of infectious organisms before the next group of sows are introduced. However, there is a need for objective pen-side diagnostic tools that can assist in confirming cleanliness. ATP bioluminescence has been used in other industries to provide real-time feedback on surface cleanliness through the detection of ATP from organic sources.
The goals of this project were to 1) determine the areas of the farrowing crate with the greatest surface contamination risks, 2) determine the correlation between microbial counts and relative light units (RLUs) as detected by ATP bioluminescence, and 3) identify the number of farrowing crate locations needed to accurately determine surface cleanliness. Traditional monitoring methods (bacterial culture, qPCR, and virus isolation) were compared to the novel ATP bioluminescence technology.
For this study, samples were collected between April and May 2024 at a 5600-sow commercial farm in western Illinois. The sow farm had recently completed a PRRSV and Mycoplasma elimination program but was experiencing frequent rotavirus outbreaks during the sampling period. The designated sow farm weaned approximately 200 litters of pigs each week and each litter averaged 12.5 weaned pigs per sow. Each farrowing room consisted of four rows of 14 crates each for a total of 56 crates per room. Approximately four farrowing rooms were washed every week.
Cleaning procedures followed farm standard operating procedure for farrowing room sanitation. Farrowing rooms were scraped to remove manure from the alleyways and farrowing crates. After most of the manure was scraped into the pit, farrowing rooms were power washed with a commercial pressure washer by farm personnel with fresh hot water set at 3000 pounds per square inch to remove any residual material. The farrowing room was then visually inspected while still wet. The room was disinfected using accelerated hydrogen peroxide at a dilution of 1:64 after it was visually determined to be clean by farm personnel.
Five crates within each room and the entryway floor were swabbed for ATP testing. Swabs were collected from six locations, including the entryway floor to the farrowing room and five areas within each crate: 1) sow feeder, 2) sorting bars, 3) back wall, 4) corners, and 5) piglet floor mat.
Swab samples were collected across a total of 21 rooms and 105 crates during the study. Twelve of the 21 rooms were sampled early in the week (Sunday, Monday, or Tuesday) and nine of the 21 rooms were sampled late in the week (Thursday, Friday, or Saturday). Additionally, 13 farrowing rooms of the 21 sampled for ATP bioluminescence were randomly selected and swabbed in the same locations for CPC to determine total colony forming units. A total of 337 environmental swabs were collected during the project. However, only 305 were included in the statistical analyses due to large variability in cleanliness outcomes that resulted in CPC values that exceeded the quantifiable threshold for the procedure.
Three ATP luminometers (Charm Sciences novaLUM II-X, 3M Clean Trace, and Neogen AccuPoint) were used to evaluate real-time testing capabilities, determine variability of RTUs within a crate and across luminometers, and estimate the relationship between ATP bioluminescence and CPC. Bacterial loads were quantified by colony forming units/100cm2 (CFM) with higher CFM indicating increased levels of bacterial contamination. The percentage of samples above 105.5 CFU/100cm2 was greatest for the entryway floor (93.8%) followed by the sow feeder (93.1%), sorting bars (49.5%), back wall (13.8%), piglet floor mat (11.8%), and corners (10.5%). This ranking gives an indication of highest risk areas in a farrowing room for bacterial contamination and cleaning needs.
Overall, this study demonstrates that ATP luminometers are a novel tool for producers to use, in conjunction with CPC testing, to objectively assess farrowing room cleanliness on-farm. The areas of greatest risk for contamination were the entryway floor and the sow feeder as indicated by both ATP bioluminescence and CPC. These results agree with previous studies showing the sow feeder is difficult to effectively clean after washing and disinfection. Entryways are a sanitation risk but may not represent room cleanliness due to constant worker foot traffic entering and exiting the room. Specifically targeting the sow feeder and piglet sorting bars for additional cleaning and disinfection would be beneficial to reducing risk and ensuring farrowing house cleanliness.

A study funded by the Swine Health Information Center Wean-to-Harvest Biosecurity Research Program, in partnership with the Foundation for Food & Agriculture Research (FFAR) and Pork Checkoff, investigated the effectiveness of rapidly deployable, exhaust fan coverings to reduce the risk of airborne particles causing transmission of swine pathogens, such as PRRSV, IAV, and PEDV. Led by Dr. Erin Kettelkamp of the Swine Vet Center, this study sought to determine the most effective material to utilize for covering fans on swine barns to enhance biosecurity and reduce the spread of diseases from farm to farm. Results of the study showed that a nylon tear-resistant fan sock was the most effective material for exhaust fan coverings at reducing large airborne particle emission from the fan surface.
Read the study’s industry summary here.
SHIC, along with FFAR, a non-profit organization established in the 2014 Farm Bill, and Pork Checkoff, partnered to develop the Wean-to-Harvest Biosecurity Program to investigate research priorities in three areas – bioexclusion (keeping disease off the farm), biocontainment (after a break, keeping disease on the farm to lessen risk to neighbors), and transportation biosecurity (live haul, culls, markets, deadstock, and feed haul along with innovative ways to stop pathogens from moving from markets and concentration points back to the farm). The goal of the program is to leverage funds to develop new tools and technologies that can enhance biosecurity in the wean-to-harvest phases of swine production.
To conduct this study, fan covers were tested at a single 2,400 head commercial, tunnel-ventilated, wean-to-finish site fully stocked with mid-finishing pigs. A single air space with one 24-inch pit fan, one 36-inch wall fan, and one 50-inch wall fan was enrolled. Three fan cover materials of varying permeability were evaluated, including PolyKlean™ synthetic air filter media (Blue Poly) that covered the fan cone, a nylon tear-resistant fan sock (Fan Sock) staked to the ground to redirect airflow, and a polyethylene privacy screen material (Black Screen) that covered the fan cone. Fan covers were compared to a fan with no cover (negative control) and materials were selected based on those that were readily available and could be rapidly deployed in an outbreak.
Airborne particle counts were collected using a handheld optical particle counter (OPC) measuring particles from 0.3 to 5.0 µm. Fan coverings were assessed for their effectiveness to reduce the number of particles when compared to the negative control. Five air particle measurements were collected 1 meter from the interior of the fan shutters and 1, 2, and 3 meters from the exterior of the fan. Three consecutive air particle measurements were performed per distance and location to calculate an average particle count, with three replicates completed for each treatment and fan. Minimum ventilation pit fans and stage two pit fans ran continuously at 100% power during sample collection. Each enrolled fan ran individually at 100% power while treatments were applied. Weather conditions were recorded at all sample locations using a portable weather station.
Under the conditions of this study, the nylon tear-resistant Fan Sock had the greatest impact on reducing air particles at 1 meter outside of the fans compared to the other fan cover treatments, especially for particles measuring 5.0 µm. Conversely, the PolyKleanTM synthetic air filter media was the least effective at reducing airborne particle emissions from fans. However, as the distance from the fan increased, differences in airborne particle quantities were not observed across the treatments, resulting in no overall differences.
These findings suggest that implementing exhaust fan coverings would be most beneficial at reducing larger air particles up to short distances (up to 1 meter) from fans. In previous studies, virus detection and infectivity tend to correlate with larger air particle sizes. For example, PRRSV and IAV have been isolated from particles greater than 2.1 µm. In the current study, fan coverings were most effective at reducing the amount of air particles ranging from 0.7 – 5.0 µm.
Based on the relationship between air particle size and the spread of airborne swine pathogens, additional research is warranted to understand the role of fan coverings on biocontainment. The fan sock provided better airflow than the other materials evaluated and is already commonly used in the swine industry, making it a more practical option for rapid deployment during disease outbreaks to improve regional biocontainment.
Overall, exhaust fan covers can provide a rapidly employable tool for swine producers to enhance wean-to-finish site biosecurity and protect swine health. Further investigation to validate these findings and explore additional biocontainment measures is warranted.
Foundation for Food & Agriculture Research
The Foundation for Food & Agriculture Research (FFAR) builds public-private partnerships to fund bold research addressing big food and agriculture challenges. FFAR was established in the 2014 Farm Bill to increase public agriculture research investments, fill knowledge gaps and complement US Department of Agriculture’s research agenda. FFAR’s model matches federal funding from Congress with private funding, delivering a powerful return on taxpayer investment. Through collaboration and partnerships, FFAR advances actionable science benefiting farmers, consumers and the environment. Connect: @FoundationFAR
Swine Health Information Center
The Swine Health Information Center, launched in 2015 with Pork Checkoff funding, protects and enhances the health of the US swine herd by minimizing the impact of emerging disease threats through preparedness, coordinated communications, global disease monitoring, analysis of swine health data, and targeted research investments. As a conduit of information and research, SHIC encourages sharing of its publications and research. Forward, reprint, and quote SHIC material freely. For more information, visit http://www.swinehealth.org or contact Dr. Megan Niederwerder at [email protected] or Dr. Lisa Becton at [email protected].

From the USDA APHIS Stakeholder Release:
APHIS Veterinary Services published the revised 2024 Japanese Encephalitis (JE) Disease Response Strategy, which can be found on the APHIS Foreign Animal Disease Preparedness and Response website.
JE is not currently found in the United States. This document is intended to provide strategic guidance for USDA, APHIS, and responders at all levels in the event of a JE outbreak, should it enter the United States. If JE is introduced into the United States, Veterinary Services will provide additional policy guidance on specific response operation activities, tailored to the conditions of the outbreak.
The 2024 Strategy updates and expands the scope of the 2013 version. Veterinary Services incorporated current science and research, shifted away from eradication as a response strategy, and updated considerations for control and vaccination. The updated version also includes more elements of the response than were previously addressed, such as a recognizing a one health approach, increasing collaboration with public health authorities, and enhancing communication plans. VS included feedback from industry and Federal One Health partners in this update.



PRRS Cumulative Incidence for MSHMP Beginning July 1, 2009

PEDV Cumulative Incidence for MSHMP Beginning May 1, 2013